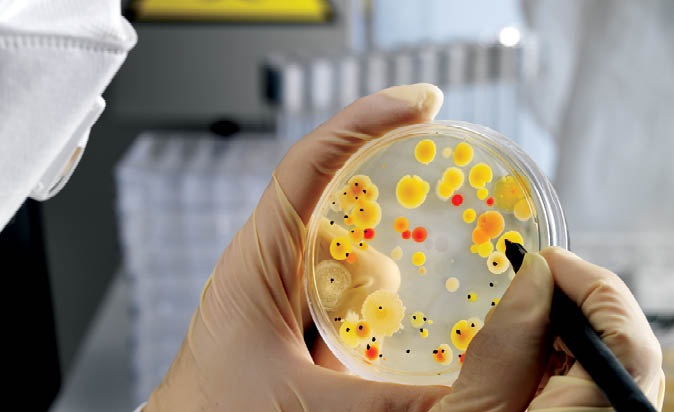

Market
Pharmaceutical Manufacturing
Pharmaceutical manufacturing is crucial because it transforms innovative drug discoveries into safe, effective treatments that improve health outcomes and advance medical science.
Streamlining APSD Testing: A New Chapter with Inhalytix Plus
One platform, full control. Inhalytix®+ centralizes APSD workflows with connected Copley equipment, audit trails, and streamlined approvals.Only Accepted Method to Replace Active and Passive Air Sampling in Grade A Cleanrooms
TSI BioTrak™ Real-Time Viable Particle Counter – the biofluorescent particle counter everyone is talking about – increases process knowledge to improve quality and eliminates viable air interventions, reducing risk and improving efficiency.Supporting the Shift to Next-Generation Propellants
Are your inhaler formulations ready for the new era of low-GWP propellants? Learn how new formulations challenge performance, and how MSP’s testing solutions help you stay compliant, precise, and ready for what’s next.ISO 17025 Accreditation Ensures Most Reliable and Highest Quality Results
ISO 17025 accreditation strengthens credibility, compliance, efficiency, and reputation by ensuring reliable, high-quality calibration services, aligning with regulatory standards, reducing costs, and enhancing customer trust in their accuracy and technical expertise.Driving Safety Through Efficient Lab Design
VAV control systems enhance lab safety by regulating airflow, temperature, and room balance while saving energy, with tailored solutions for fume hoods, open, enclosed, teaching, and high containment labs.
Advanced Solutions for Life Science Professionals, Helping Ensure Product Quality, Safety, and Efficiency.
Market
Pharmaceutical Manufacturing
Pharmaceutical manufacturing is crucial because it transforms innovative drug discoveries into safe, effective treatments that improve health outcomes and advance medical science.

Market
Biologics
Biologics is crucial for ensuring the safety, efficacy, and purity of therapeutic products, protecting both patient health and the integrity of the drug development process.
Market
Medical Devices
High-quality, precise medical devices are essential for accurate diagnostics, effective treatment, patient monitoring and innovative research and development.

Market
Research
Critical research advances our knowledge and ability to address biological challenges and improve quality of life through development of new technologies and treatments to improve quality of life.

The Case for Facility Monitoring Systems
Maximizing Quality, Reducing Waste, and Ensuring Compliance
Facility Monitoring Systems enhance product quality, increase profitability, and minimize risk by providing real-time data and proactive insights, ensuring compliance with regulations and supporting cost-effective, safe, and efficient manufacturing.


Maintain Smooth and Compliant Operations
Maximize Your Equipment’s Performance with MSP’s Annual Calibration

Maintain Smooth and Compliant Operations
Maximize Your Equipment’s Performance with MSP’s Annual Calibration
The United States Pharmacopeia (USP 1058) and Good Manufacturing Practices (GMP) recommend initial and periodic mensuration and calibration to ensure proper operation.